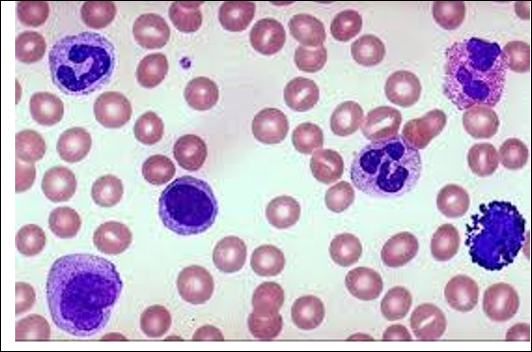
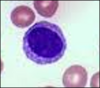
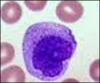
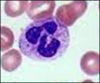

What are the 4 blood type groups
A, B, AB, O
Which antigens are on the surface of RBC’s
A and B antigen
ident. and what they do

stimulated blood sample by name, unknown for testing for blood type/antigen
3 different serums together PICTURE

will cause agglutination clumping when they detect the corresponding antigen
LAB2 HEMATOLOGY plastic tray
blood and anti-sera are well mixed
LAB 2 HEMATOLOGY Toothpicks
used for mixing the liquids , new one for each well to prevent cross contamination
Which blood type is this ?

B
which blood type is this?

O
which blood type is this ?

A
what blood types can donate to a person with a blood type of AB?
All
what antibodies are in the plasma of someone with type O
both Anti A and B
Name the preparation of the slide
blood smear
LAB 2 HEMATOLOGY
what blood cells are agranular ?
monocytes and lymphocytes
name this machine

hemoglobinometer
what does it measure

amount of hemoglobin in whole blood G/dL
what is the normal range of hemoglobin for males ?
14-18g/dL
what is the range for females ? Hemoglobin
12-16
is this a normal hemoglobin for a female? 12.9 ?
yes
LAB 3 HEMATOLOGY name this test

hematocrit
name the following materials and what they are for

microcentrifuge& spins the capillary tube to pack the red blood cells
name the following materials and what they are for

heparinized capillary tubes& holds the blood sample and heparin prevents clotting
name the following materials and what they are for

critoseal & clay to plug one open end of the capillary tube during centrifugation
LAB 3 calculate the hematocrit
Length of packed blood cells in tube (mm)
Total length of blood column in tube (mm) x 100 = % hematocrit

32.8 %
LAB3 HEMAcrit follow up is 32.8 % normal for a male ?
no , the normal range is 42-52